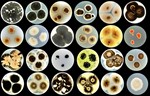

Početna
>>Završna obrada, enterijer
>>Oblaganje, sredstva za završnu obradu
>>Malter
>>Malter termoizolacioni
Malter termoizolacioni

ILGRAD BEOGRAD-PINOSAVA, SRB
011 3908 178
Preduzeće ILGRAD je porodična firma koja postoji od 1995. godine i bavi se proizvodnjom materijala za završne radove u građevinarstvu - lepkova, fasadnih maltera i glet-masa.
U okviru proizvodnog programa izdvojilo se nekoliko proizvoda koji su po ...
ADING NOVI BEOGRAD, SRB
011 6279 338
BAUMIT BEOGRAD-ZEMUN, SRB
011 3475 079
BAUMIT SARAJEVO-ILIDŽA, BIH
+387 33 566770
BELINA BOJE NIŠ, SRB
018 577 341
BUTTERFLY LINE 1974 BEOGRAD, SRB
011 3435 797
CEMENTNI PROIZVODI VLASOTINCE, SRB
016 875 100
CREDICOM INTERNATIONAL BEOGRAD, SRB
011 3292 429
DANI FAMILY KOVIN, SRB
013 744 851
HENKEL SRBIJA BEOGRAD, SRB
011 2072 250
INES SMEDEREVO, SRB
026 4628 540
JO GO DESIGN STUDIO BEOGRAD-PALILULA, SRB
011 2979 107
KOLOR NOVI SAD-VETERNIK, SRB
021 823 707
KRAS LAKTAŠI, BIH
+387 51 532264
MVD KRSTIĆ BEOGRAD, SRB
011 2773 319
PARTIZAN USLUŽNI CENTAR BEOGRAD, SRB
011 2511 577
RIWEX ZVORNIK, BIH
+387 56 231460
ROFIX LJUBUŠKI, BIH
+387 39 830100
ROFIX PARAĆIN-POPOVAC, SRB
035 541 702
TERMIKA ZRENJANIN, SRB
023 543 020
}

 08.06.2026.
Qbiss Notch osvojio Red Dot Design Award
08.06.2026.
Qbiss Notch osvojio Red Dot Design Award

 13.05.2026.
Podovi projektovani za najzahtevnije industrijske uslove: Čvrsti temelji savremene indust...
13.05.2026.
Podovi projektovani za najzahtevnije industrijske uslove: Čvrsti temelji savremene indust...

 30.04.2026.
Inovativni fasadni sistem jednostavan za primenu
30.04.2026.
Inovativni fasadni sistem jednostavan za primenu

 26.03.2026.
Idealno rešenje za eksterijer: Sinterovani kamen za kompletno spoljašnje uređenje
26.03.2026.
Idealno rešenje za eksterijer: Sinterovani kamen za kompletno spoljašnje uređenje

 30.01.2026.
Foto tapete za dekoraciju zidova: Zaboravljeni detalj ponovo u trendu
30.01.2026.
Foto tapete za dekoraciju zidova: Zaboravljeni detalj ponovo u trendu

 16.01.2026.
Sve za opremanje hotela i restorana na jednom mestu
16.01.2026.
Sve za opremanje hotela i restorana na jednom mestu

 12.11.2025.
Održiva rešenja za obnovu fasada su spoj inovacije i odgovornosti
12.11.2025.
Održiva rešenja za obnovu fasada su spoj inovacije i odgovornosti

 22.07.2025.
Nova dimenzija podova uz Barlinek
22.07.2025.
Nova dimenzija podova uz Barlinek

 15.07.2025.
Kako odabrati idealne pločice za kupatilo
15.07.2025.
Kako odabrati idealne pločice za kupatilo

 26.06.2025.
Ferobeton i industrijski podovi - Savršeno rešenje za trajnost i pouzdanost
26.06.2025.
Ferobeton i industrijski podovi - Savršeno rešenje za trajnost i pouzdanost

 25.06.2025.
Paralline - Malo truda da svoj dom učinite jedinstvenim
25.06.2025.
Paralline - Malo truda da svoj dom učinite jedinstvenim

 07.05.2024.
Unesite novu energiju u vaš dom
07.05.2024.
Unesite novu energiju u vaš dom

 29.02.2024.
Da li je bolji standardni ili višeslojni parket?
29.02.2024.
Da li je bolji standardni ili višeslojni parket?

 29.01.2024.
Kako uvesti vodu u kuću tamo gde nema javnog vodovoda
29.01.2024.
Kako uvesti vodu u kuću tamo gde nema javnog vodovoda

 28.11.2023.
Od zidova do podova: Kako urediti enterijer do perfekcije?
28.11.2023.
Od zidova do podova: Kako urediti enterijer do perfekcije?
 26.05.2025.
Žive tetovaže za zgrade: Mikrobi štite fasade od zagađenja
26.05.2025.
Žive tetovaže za zgrade: Mikrobi štite fasade od zagađenja
 03.04.2025.
Pločice od micelijuma za pasivno hlađenje zgrada - inovacija inspirisana kožom slona
03.04.2025.
Pločice od micelijuma za pasivno hlađenje zgrada - inovacija inspirisana kožom slona
 03.10.2024.
Ekološki podni paneli od bioplastike i drvnog otpada
03.10.2024.
Ekološki podni paneli od bioplastike i drvnog otpada
 14.08.2024.
Pametna fotonaponska fasada smanjuje potrošnju energije do 80%
14.08.2024.
Pametna fotonaponska fasada smanjuje potrošnju energije do 80%
 25.12.2023.
Zidne obloge od mlevenih klipova kukuruza
25.12.2023.
Zidne obloge od mlevenih klipova kukuruza

PROMO TEKSTOVI /iz kategorije/
ISTAKNUTE FIRME /iz kategorije/
Anketa
Kojom vrstom toplotne izolacije je izolovan vaš stan/kuća?
Dragan
01.04.2026.
Još jedan primer potpuno pogrešnog postavlj...
Dragan
30.03.2026.
Radio sam u veleprodaji građevinskog materi...
Мик
25.03.2026.
Како ван урбаног дела насеља ако пролази кр...
Dzi
26.01.2026.
Uvek raduje svaka lepa vest iz Afrike...nar...
Darko
26.01.2026.
Da li je ispunjen Član 26 Zakona:
Podzak...















 ;
;